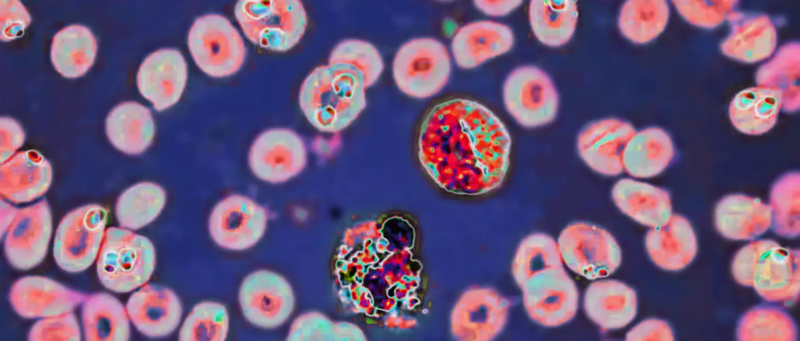

Another mystery disease outbreak in the Democratic Republic of Congo has emerged, resulting in at least 60 deaths, health officials say.
It follows a similar event in September 2024, referred to as “Disease X” before the World Health Organization (WHO) identified it as a cocktail of several known acute respiratory illnesses complicated by malaria and malnutrition.
These new outbreaks could have similar origins, but it will likely take time to determine exactly what the cause is.
Toxic contamination is also considered a possible cause.
What is the current situation in the DR Congo?
More than 1,000 cases have been reported across the DR Congo’s Equateur province and 141 cases of a disease have been reported in Basankusu’s health zone. A separate outbreak in early February consisted of 158 cases and 58 deaths.
In January, Bolamba village reported 12 cases and eight deaths.
What have initial tests shown?
Health authorities in the DR Congo and WHO experts are carrying out investigations to determine the cause of the illness and deaths.
Early lab tests ruled out Ebola and Marburg disease. Half of those tested have tested positive for malaria.
“We’re not really satisfied with the sampling, so we’ve sent two WHO epidemiologists up there,” Margaret Harris, a WHO spokesperson, told DW News.
“They’re up there now and they’re overseeing the sampling and getting them back to the laboratories in [DR Congo’s capital] Kinshasa.”
Further testing is being undertaken for meningitis and potential toxic contamination.
WHO emergencies director Mike Ryan, along with local health authorities, favor the latter as a cause.
“It would appear that we have some kind of poisoning event,” Ryan told reporters.
Do officials know the source of the outbreak?
The cause of the disease — and whether the illnesses in different regions are connected — remains unknown.
Early reports suggested the first cases were among a group of children who may have eaten a bat, though this incident is not yet confirmed as the cause of the outbreak.
Bats are known reservoirs of viruses and other disease-causing pathogens. Global health advice recommends people steer clear of exposure to dead animals.
Although the main outbreak villages of Basankusu and Bolomba are 116 miles (186 kilometers) apart, it’s unclear if the disease outbreaks share the same cause.
What are the symptoms of the mystery disease?
The WHO’s latest memo says symptoms are broad, and include fever, headaches, chills, sweating, stiffness in the neck, muscular aches, joint and body pain, coughing, vomiting and diarrhea.
The broadness of these symptoms and their potential to apply to many diseases makes it impossible to pinpoint the cause without analysis of biological samples from patients.
Some health experts believe the mystery disease is likely caused by several known pathogens acting together.
That malaria has been found in one in two cases already is important information for health authorities, but the addition of further sampling and analysis by WHO officials in conjunction with local teams will help narrow the search for a cause.
“Tests are never 100% accurate, and it is likely that with increased testing, we will have a confirmed pathogen in some of those samples,” said Michael Head, an epidemiologist at the University of Southampton, UK.
Could the disease spread further?
Health infrastructure in this region of the DR Congo is limited, and there are concerns that the disease could spread. As with the malaria-respiratory infections that caused the 2024 outbreak, malnutrition and other underlying conditions can increase the chances of death.
Local health authorities have been addressing Mpox and Ebola outbreaks in recent years, so Head suggests the challenges of limited infrastructure to manage new diseases can be offset by their “experience at addressing infectious disease epidemics.”
Source : https://www.dw.com/en/another-mystery-disease-outbreak-in-dr-congo-what-we-know/a-71783032











